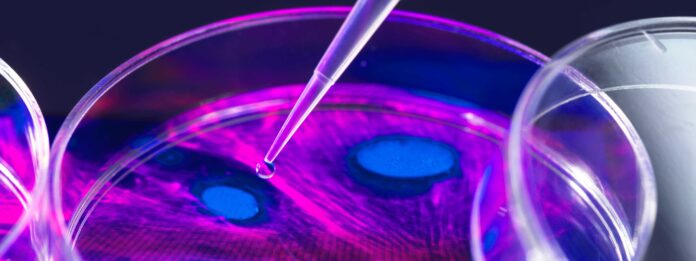
Opportunities in AI | White & Case LLP

In the evolving landscape of life sciences, AI is emerging as a vital innovator, streamlining processes from drug design to clinical trials. A recent survey reveals that 56% of human pharma respondents believe personalized medicine and clinical trial optimization will significantly influence strategies. AI enhances efficiency by aiding in patient identification, site selection, and trial management. For healthcare providers, operational efficiency (62%) is paramount, followed by trial optimization (58%) and remote monitoring (52%). Medical device companies see AI’s benefits in quality system optimization (56%) and detecting compliance issues. Additionally, AI fosters collaboration and reduces costs in product design, supporting earlier adjustments and better alignment among teams. In commercialization, AI-driven data insights enable companies to tailor marketing and accelerate product launches, improving patient engagement. Ultimately, AI’s role in life sciences is transformative, offering real-time decision-making capabilities that promise to reshape the industry’s future.
Source link
Share
Read more